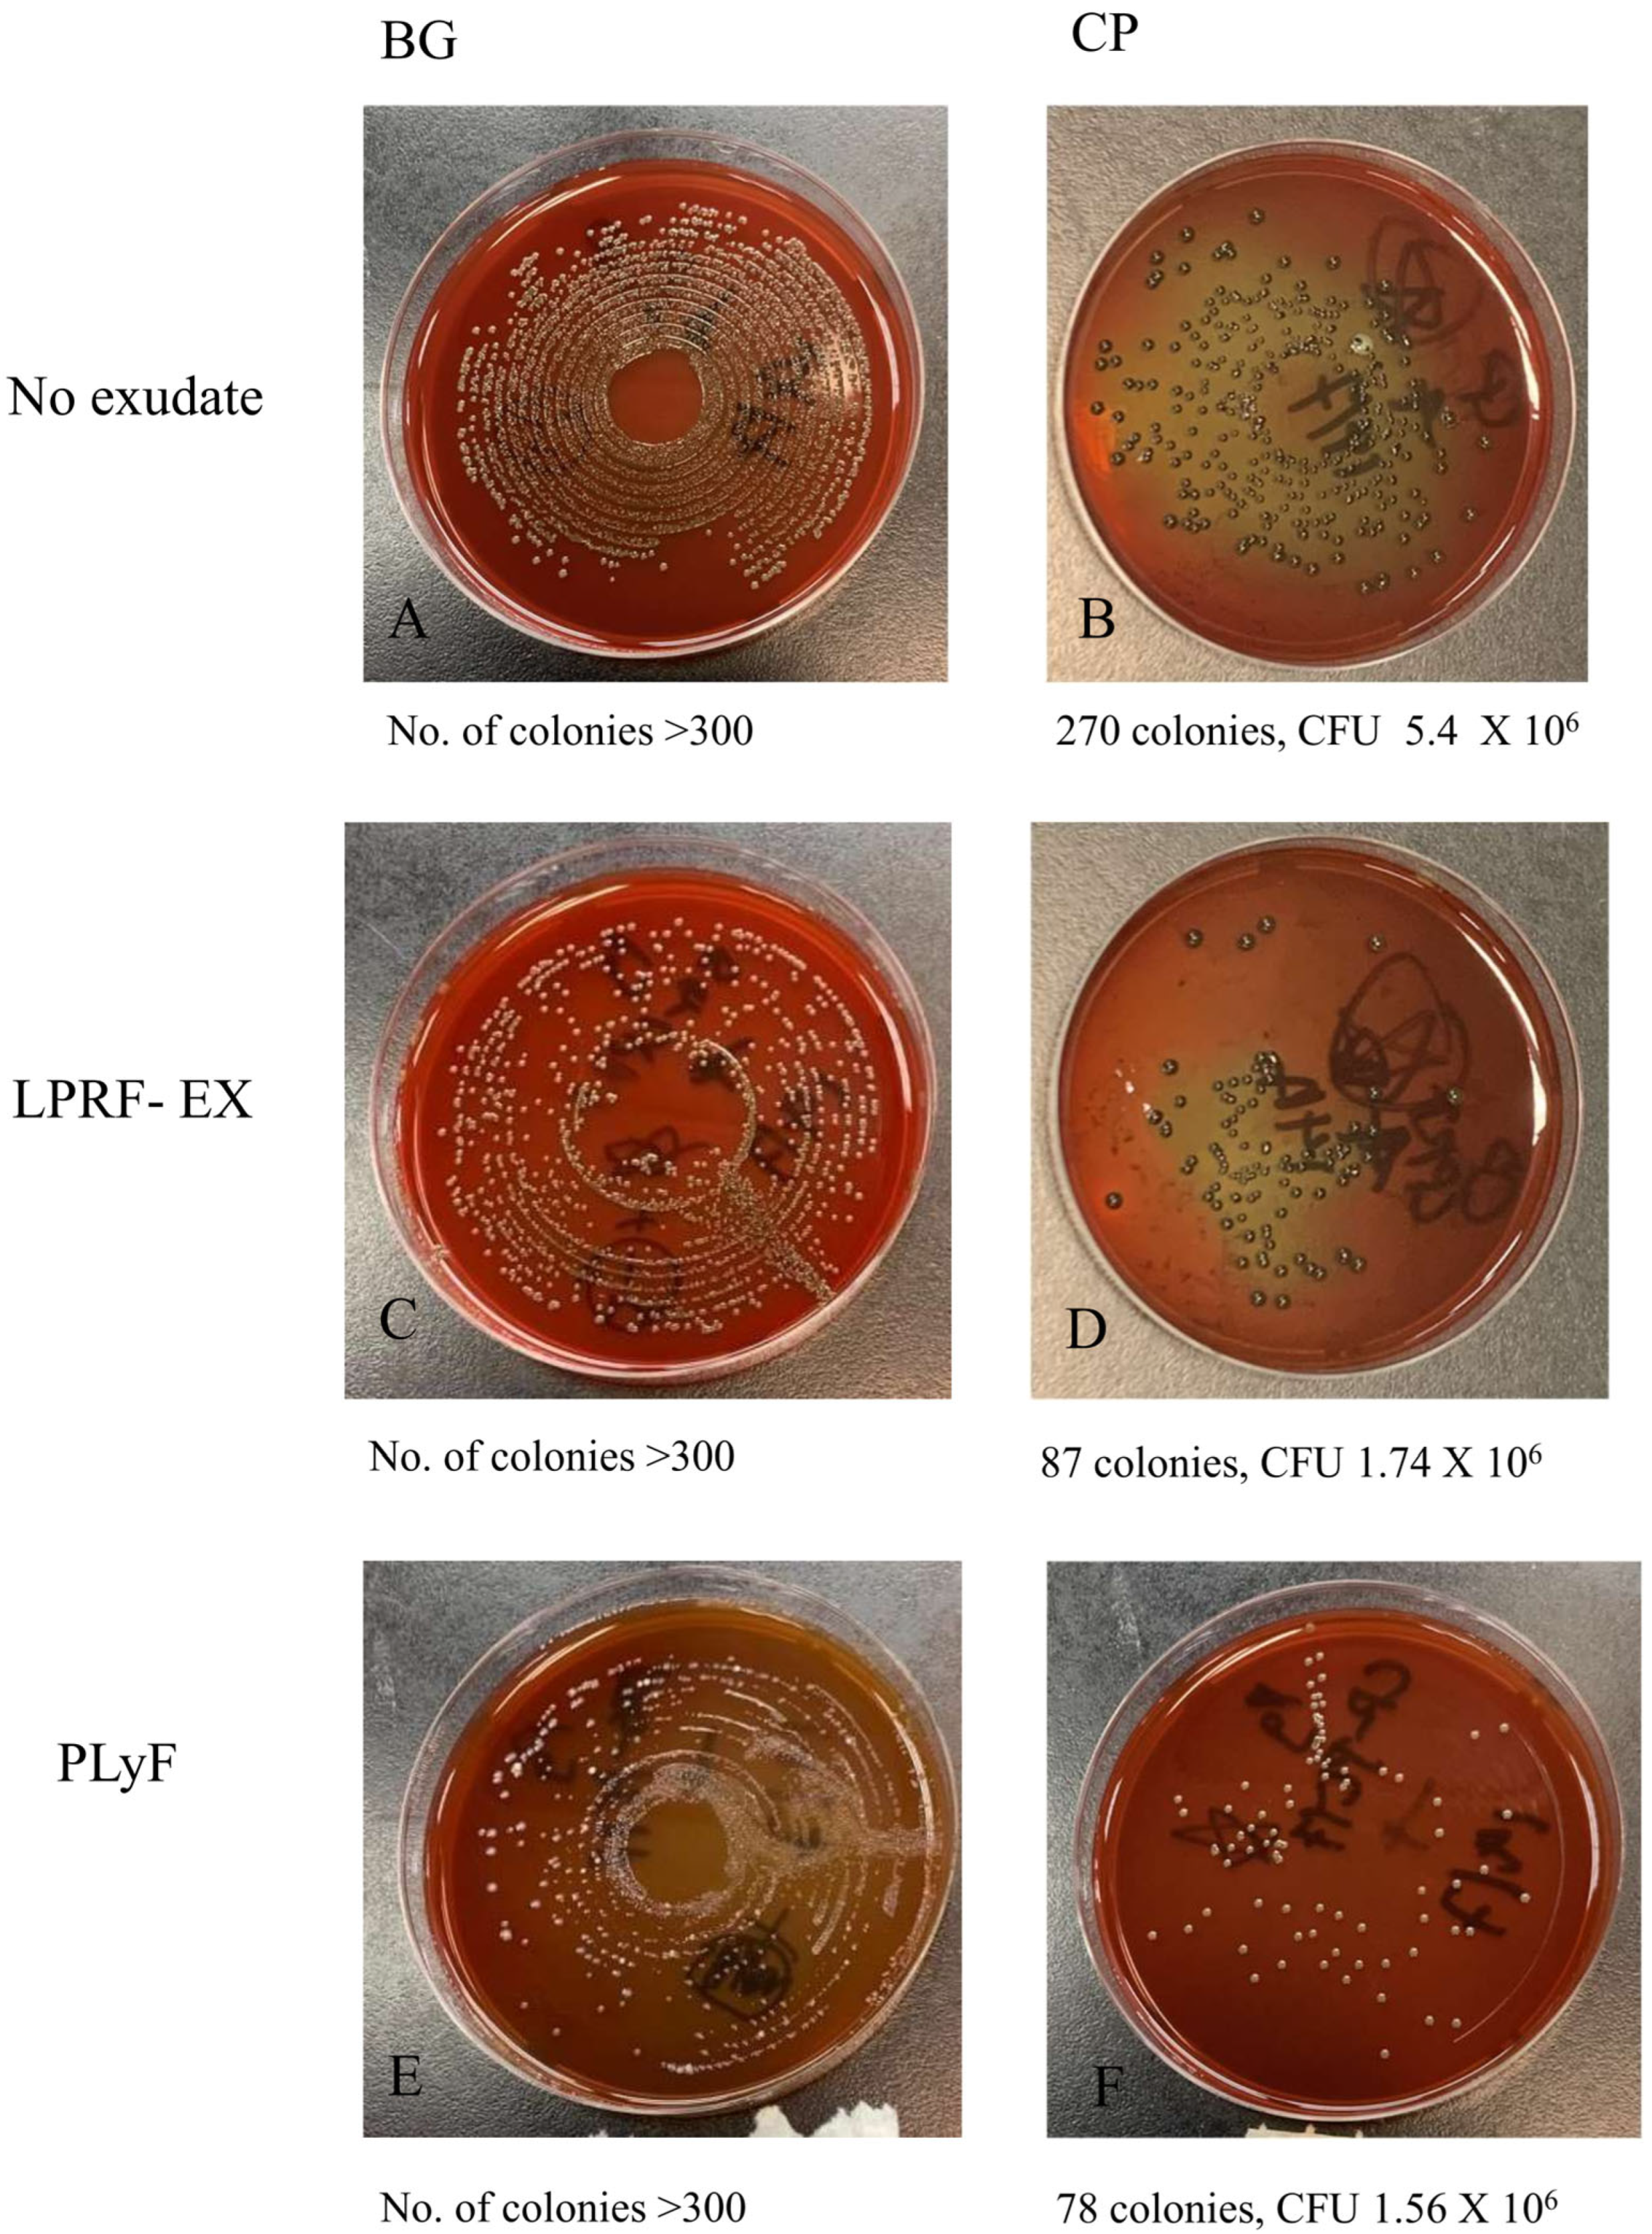
Dentistry 13 00228 g007

In Vitro Evaluation of the Antibacterial Properties and Cellular Response of Liquid-Leukocyte Platelet-Rich Fibrin Products on Barrier Membranes: A Pilot Study
Abstract
1. Introduction
2. Results
2.1. HGF Cell-Culture Experiments
2.1.1. SEM Analysis of Untreated BM
2.1.2. SEM Analysis of Treated Membrane with HGF Cell Culture
2.1.3. HGF Cell Proliferation Assays
2.2. Oral Bacterial Culture Experiments
2.2.1. Bacterial Adhesion on BMs Examined by SEM
2.2.2. Bacterial CFU Counts
3. Discussion
4. Materials and Methods
4.1. Subject Recruitment, Inclusion and Exclusion Criteria
4.2. Preparation of L-PRF Products
4.3. Preparation and Treatment of BMs
4.4. Human Gingival Fibroblast (HGF) Cell-Culture Experiments
4.4.1. Cells and Culture
4.4.2. Scanning Electron Microscopy for Fibroblast Adhesion
4.4.3. Cell Proliferation Assays
4.5. Oral Bacterial Infection Experiments
4.5.1. Bacterial Culture
4.5.2. Scanning Electron Microscopy (SEM) (Hitachi™ VP-SEM SU1510, Hitachi, Tokyo, Japan) for Bacterial Adhesion
4.5.3. Colony-Forming Unit (CFU) Counts
4.6. Data Analysis
Author Contributions
Funding
Institutional Review Board Statement
Informed Consent Statement
Data Availability Statement
Acknowledgments
Conflicts of Interest
Abbreviations
References
- Amrollahi, P.; Shah, B.; Seifi, A.; Tayebi, L. Recent advancements in regenerative dentistry: A review. Mater. Sci. Eng. C Mater. Biol. Appl. 2016, 69, 1383–1390. [Google Scholar] [CrossRef] [PubMed]
- Mehta, D.B.; Deshpande, N.C.; Dandekar, S.A. Comparative Evaluation of Platelet-Rich Fibrin Membrane and Collagen Membrane along with Demineralized Freeze-Dried Bone Allograft in Grade II Furcation Defects: A Randomized Controlled Study. J. Indian Soc. Periodontol. 2018, 22, 322–327. [Google Scholar] [PubMed]
- Marx, R.E.; Carlson, E.R.; Eichstaedt, R.M.; Schimmele, S.R.; Strauss, J.E.; Georgeff, K.R. Platelet-rich plasma: Growth factor enhancement for bone grafts. Oral Surg. Oral Med. Oral Pathol. Oral Radiol. Endod. 1998, 85, 638–646. [Google Scholar] [CrossRef]
- Whitman, D.H.; Berry, R.L.; Green, D.M. Platelet gel: An autologous alternative to fibrin glue with applications in oral and maxillofacial surgery. J. Oral Maxillofac. Surg. 1997, 55, 1294–1299. [Google Scholar] [CrossRef]
- Dohan Ehrenfest, D.M.; Del Corso, M.; Diss, A.; Mouhyi, J.; Charrier, J.B. Three-dimensional architecture and cell composition of a Choukroun’s platelet-rich fibrin clot and membrane. J. Periodontol. 2010, 81, 546–555. [Google Scholar] [CrossRef]
- Dohan Ehrenfest, D.M. How to optimize the preparation of leukocyte- and platelet-rich fibrin (L-PRF, Choukroun’s technique) clots and membranes: Introducing the PRF Box. Oral Surg. Oral Med. Oral Pathol. Oral Radiol. Endod. 2010, 110, 275–280. [Google Scholar] [CrossRef]
- Ghanaati, S.; Booms, P.; Orlowska, A.; Kubesch, A.; Lorenz, J.; Rutkowski, J.; Landes, C.; Sader, R.; Kirkpatrick, C.; Choukroun, J. Advanced Platelet-Rich Fibrin: A New Concept for Cell-Based Tissue Engineering by Means of Inflammatory Cells. J. Oral Implantol. 2014, 40, 679–689. [Google Scholar] [CrossRef]
- Dohan, D.M.; Choukroun, J.; Diss, A.; Dohan, S.L.; Dohan, A.J.; Mouhyi, J.; Gogly, B. Platelet-rich fibrin (PRF): A second-generation platelet concentrate. Part II: Platelet-related biologic features. Oral Surg. Oral Med. Oral Pathol. Oral Radiol. Endod. 2006, 101, e45–e50. [Google Scholar] [CrossRef]
- Bielecki, T.; Dohan Ehrenfest, D.M.; Everts, P.A.; Wiczkowski, A. The role of leukocytes from L-PRP/L-PRF in wound healing and immune defense: New perspectives. Curr. Pharm. Biotechnol. 2012, 13, 1153–1162. [Google Scholar] [CrossRef]
- Crisci, A. The L-PRF membrane (fibrin rich in platelets and leukocytes) and its derivatives (A-PRF, I-PRF) are useful as a source of stem cells in regenerative wound therapy: Experimental work on the horse. Regen. Med. Ther. 2019, 3, 37–45. [Google Scholar] [CrossRef]
- He, L.; Lin, Y.; Hu, X.; Zhang, Y.; Wu, H. A comparative study of platelet-rich fibrin (PRF) and platelet-rich plasma (LPRF) on the effect of proliferation and differentiation of rat osteoblasts in vitro. Oral Surg. Oral Med. Oral Pathol. Oral Radiol. Endod. 2009, 108, 707–713. [Google Scholar] [CrossRef] [PubMed]
- Fujioka-Kobayashi, M.; Miron, R.J.; Hernandez, M.; Kandalam, U.; Zhang, Y.; Choukroun, J. Optimized platelet-rich fibrin with the low-speed concept: Growth factor release, biocompatibility, and cellular response. J. Periodontol. 2017, 88, 112–121. [Google Scholar] [CrossRef]
- Rodríguez Sánchez, F.; Verspecht, T.; Castro, A.B.; Pauwels, M.; Andrés, C.R.; Quirynen, M.; Teughels, W. Antimicrobial Mechanisms of Leucocyte- and Platelet Rich Fibrin Exudate Against Planktonic Porphyromonas gingivalis and Within Multi-Species Biofilm: A Pilot Study. Front. Cell. Infect. Microbiol. 2021, 11, 722499. [Google Scholar] [CrossRef]
- Dohan Ehrenfest, D.M.; Pinto, N.R.; Pereda, A.; Jiménez, P.; Corso, M.D.; Kang, B.S.; Nally, M.; Lanata, N.; Wang, H.L.; Quirynen, M. The impact of the centrifuge characteristics and centrifugation protocols on the cells, growth factors, and fibrin architecture of a leukocyte-and platelet-rich fibrin (L-PRF) clot and membrane. Platelets 2018, 29, 171–184. [Google Scholar] [CrossRef]
- Serafini, G.; Lopreiato, M.; Lollobrigida, M.; Lamazza, L.; Mazzucchi, G.; Fortunato, L.; Mariano, A.; Scotto d’Abusco, A.; Fontana, M.; De Biase, A. Platelet Rich Fibrin (PRF) and Its Related Products: Biomolecular Characterization of the Liquid Fibrinogen. J. Clin. Med. 2020, 9, 1099. [Google Scholar] [CrossRef]
- Ratajczak, J.; Vangansewinkel, T.; Gervois, P.; Merckx, G.; Hilkens, P.; Quirynen, M.; Lambrichts, I.; Bronckaers, A. Angiogenic Properties of ‘Leukocyte- and Platelet-Rich Fibrin’. Sci. Rep. 2018, 8, 14632. [Google Scholar] [CrossRef]
- Blanco, J.; García Alonso, A.; Hermida-Nogueira, L.; Castro, A.B. How to explain the beneficial effects of leukocyte-and platelet-rich fibrin. Periodontol. 2000 2025, 97, 74–94. [Google Scholar] [CrossRef]
- Miron, R.J.; Fujioka-Kobayashi, M.; Hernandez, M.; Kandalam, U.; Zhang, Y.; Ghanaati, S.; Choukroun, J. Injectable platelet rich fibrin (i-PRF): Opportunities in regenerative dentistry? Clin. Oral Investig. 2017, 21, 2619–2627. [Google Scholar] [CrossRef]
- Wang, X.; Zhang, Y.; Choukroun, J.; Ghanaati, S.; Miron, R.J. Effects of an injectable platelet-rich fibrin on osteoblast behavior and bone tissue formation in comparison to platelet-rich plasma. Platelets 2018, 29, 48–55. [Google Scholar] [CrossRef]
- Dahlin, C.; Linde, A.; Gottlow, J.; Nyman, S. Healing of bone defects by guided tissue regeneration. Plastic and reconstructive surgery. Plast. Reconstr. Surg. 1988, 81, 672–676. [Google Scholar] [CrossRef]
- Bianchi, S.; Bernardi, S.; Simeone, D.; Torge, D.; Macchiarelli, G.; Marchetti, E. Proliferation and morphological assessment of human periodontal ligament fibroblast towards bovine pericardium membranes: An in vitro study. Materials 2022, 15, 8284. [Google Scholar] [CrossRef]
- Pistilli, R.; Simion, M.; Barausse, C.; Gasparro, R.; Pistilli, V.; Bellini, P.; Felice, P. Guided Bone Regeneration with Nonresorbable Membranes in the Rehabilitation of Partially Edentulous Atrophic Arches: A Retrospective Study on 122 Implants with a 3- to 7-Year Follow-up. Int. J. Periodontics Restor. Dent. 2020, 40, 685–692. [Google Scholar] [CrossRef] [PubMed]
- Rocchietta, I.; Fontana, F.; Simion, M. Clinical outcomes of vertical bone augmentation to enable dental implant placement: A systematic review. J. Clin. Periodontol. 2008, 35 (Suppl. S8), 203–215. [Google Scholar] [CrossRef] [PubMed]
- Benic, G.I.; Hämmerle, C.H. Horizontal bone augmentation by means of guided bone regeneration. Periodontol. 2000 2014, 66, 13–40. [Google Scholar] [CrossRef] [PubMed]
- Abdo, V.L.; Suarez, L.J.; de Paula, L.G.; Costa, R.C.; Shibli, J.; Feres, M.; Barão, V.-R.; Bertolini, M.; Souza, J.-S. Underestimated microbial infection of resorbable membranes on guided regeneration. Colloids Surf. B Biointerfaces 2023, 226, 113318. [Google Scholar] [CrossRef]
- Slutzkey, S.; Kozlovsky, A.; Artzi, Z.; Matalon, S. Collagen barrier membranes may accelerate bacterial growth in vitro: A potential clinical risk to regenerative procedures. Quintessence Int. 2015, 46, 43–50. [Google Scholar] [CrossRef]
- Machtei, E.E. The effect of membrane exposure on the outcome of regenerative procedures in humans: A meta-analysis. J. Periodontol. 2001, 72, 512–516. [Google Scholar] [CrossRef]
- Garcia, J.; Dodge, A.; Luepke, P.; Wang, H.L.; Kapila, Y.; Lin, G.H. Effect of membrane exposure on guided bone regeneration: A systematic review and meta-analysis. Clin. Oral Implant. Res. 2018, 29, 328–338. [Google Scholar] [CrossRef]
- Urban, I.A.; Montero, E.; Monje, A.; Sanz-Sánchez, I. Effectiveness of vertical ridge augmentation interventions: A systematic review and meta-analysis. J. Clin. Periodontol. 2019, 46 (Suppl. S21), 319–339. [Google Scholar] [CrossRef]
- Omar, O.; Elgali, I.; Dahlin, C.; Thomsen, P. Barrier membranes: More than the barrier effect? J. Clin. Periodontol. 2019, 46, 103–123. [Google Scholar] [CrossRef]
- Mozgan, E.M.; Edelmayer, M.; Janjić, K.; Pensch, M.; Fischer, M.B.; Moritz, A.; Agis, H. Release kinetics and mitogenic capacity of collagen barrier membranes supplemented with secretome of activated platelets—The in vitro response of fibroblasts of the periodontal ligament and the gingiva. BMC Oral Health 2017, 17, 66. [Google Scholar] [CrossRef] [PubMed]
- Huang, Q.; Huang, X.; Gu, L. Periodontal Bifunctional Biomaterials: Progress and Perspectives. Materials 2021, 14, 7588. [Google Scholar] [CrossRef]
- Toledano-Osorio, M.; Vallecillo, C.; Vallecillo-Rivas, M.; Manzano-Moreno, F.J.; Osorio, R. Antibiotic-Loaded Polymeric Barrier Membranes for Guided Bone/Tissue Regeneration: A Mini-Review. Polymers 2022, 14, 840. [Google Scholar] [CrossRef]
- Mudalal, M.; Wang, Z.; Mustafa, S.; Liu, Y.; Wang, Y.; Yu, J.; Wang, S.; Sun, X.; Zhou, Y. Effect of Leukocyte-Platelet Rich Fibrin (L-PRF) on tissue regeneration and proliferation of human gingival fibroblast cells cultured using a modified method. Tissue Eng. Regen. Med. 2021, 18, 895–904. [Google Scholar] [CrossRef]
- Goel, A.; Windsor, L.J.; Gregory, R.L.; Blanchard, S.B.; Hamada, Y. Effects of platelet-rich fibrin on human gingival and periodontal ligament fibroblast proliferation from chronic periodontitis versus periodontally healthy subjects. Clin. Exp. Dent. Res. 2021, 7, 436–442. [Google Scholar] [CrossRef]
- Quirynen, M.; Siawasch, S.; Temmerman, A.; Cortellini, S.; Dhondt, R.; Teughels, W.; Castro, A.B. Do autologous platelet concentrates (APCs) have a role in intra-oral bone regeneration? A critical review of clinical guidelines on decision-making process. Periodontol. 2000 2023, 93, 254–269. [Google Scholar] [CrossRef]
- Işık, G.; Özden Yüce, M.; Koçak-Topbaş, N.; Günbay, T. Guided bone regeneration simultaneous with implant placement using bovine-derived xenograft with and without liquid platelet-rich fibrin: A randomized controlled clinical trial. Clin. Oral Investig. 2021, 25, 5563–5575. [Google Scholar] [CrossRef]
- Apaza Alccayhuaman, K.A.; Heimel, P.; Tangl, S.; Lettner, S.; Kampleitner, C.; Panahipour, L.; Kuchler, U.; Gruber, R. Human versus Rat PRF on Collagen Membranes: A Pilot Study of Mineralization in Rat Calvaria Defect Model. Bioengineering 2024, 11, 414. [Google Scholar] [CrossRef]
- Al-Maawi, S.; Herrera-Vizcaíno, C.; Orlowska, A.; Willershausen, I.; Sader, R.; Miron, R.J.; Choukroun, J.; Ghanaati, S. Biologization of Collagen-Based Biomaterials Using Liquid-Platelet-Rich Fibrin: New Insights into Clinically Applicable Tissue Engineering. Materials 2019, 12, 3993. [Google Scholar] [CrossRef]
- Blatt, S.; Schröger, S.-V.; Pabst, A.; Kämmerer, P.W.; Sagheb, K.; Al-Nawas, B. Biofunctionalization of Xenogeneic Collagen Membranes with Autologous Platelet Concentrate—Influence on Rehydration Protocol and Angiogenesis. Biomedicines 2022, 10, 706. [Google Scholar] [CrossRef]
- Sato, T.; Watanabe, K.; Kumada, H.; Toyama, T.; Tani-Ishii, N.; Hamada, N. Peptidoglycan of Actinomyces naeslundii induces inflammatory cytokine production and stimulates osteoclastogenesis in alveolar bone resorption. Arch. Oral Biol. 2012, 57, 1522–1528. [Google Scholar] [CrossRef] [PubMed]
- Lunar Silva, I.; Cascales, E. Molecular Strategies Underlying Porphyromonas gingivalis Virulence. J. Mol. Biol. 2021, 433, 166836. [Google Scholar] [CrossRef]
- Karde, P.A.; Sethi, K.S.; Mahale, S.A.; Khedkar, S.U.; Patil, A.G.; Joshi, C.P. Comparative evaluation of platelet count and antimicrobial efficacy of injectable platelet-rich fibrin with other platelet concentrates: An in vitro study. J. Indian Soc. Periodontol. 2017, 21, 97–101. [Google Scholar] [CrossRef]
- Sindhusha, V.B.; Ramamurthy, J. Comparison of Antimicrobial Activity of Injectable Platelet-Rich Fibrin (i-PRF) and Leukocyte and Platelet-Rich Fibrin (l-PRF) Against Oral Microbes: An In Vitro Study. Cureus 2023, 15, e46196. [Google Scholar] [CrossRef]
- Wu, J.; Yu, P.; Lv, H.; Yang, S.; Wu, Z. Nanostructured Zirconia Surfaces Regulate Human Gingival Fibroblasts Behavior Through Differential Modulation of Macrophage Polarization. Front. Bioeng. Biotechnol. 2021, 8, 611684. [Google Scholar] [CrossRef]
- Osman, M.A.; Kushnerev, E.; Alamoush, R.A.; Seymour, K.G.; Yates, J.M. Two Gingival Cell Lines Response to Different Dental Implant Abutment Materials: An In Vitro Study. Dent. J. 2022, 10, 192. [Google Scholar] [CrossRef]
- Melo-Ferraz, A.; Coelho, C.; Miller, P.; Criado, M.B.; Monteiro, M.C. Comprehensive analysis of L-PRF exudate components and their impact on whole blood platelets. Clin. Oral Investig. 2024, 28, 470. [Google Scholar] [CrossRef]
- Imani, A.; Panahipour, L.; Kühtreiber, H.; Mildner, M.; Gruber, R. RNAseq of Gingival Fibroblasts Exposed to PRF Membrane Lysates and PRF Serum. Cells 2024, 13, 1308. [Google Scholar] [CrossRef]
- Lollobrigida, M.; Maritato, M.; Bozzuto, G.; Formisano, G.; Molinari, A.; De Biase, A. Biomimetic implant surface functionalization with liquid L-PRF products: In vitro study. BioMed Res. Int. 2018, 2018, 9031435. [Google Scholar] [CrossRef]
- Blatt, S.; Krüger, M.; Kämmerer, P.W.; Thiem, D.G.; Matheis, P.; Eisenbeiß, A.K.; Wiltfang, J.; Al-Nawas, B.; Naujokat, H. Non-Interventional Prospective Observational Study of Platelet Rich Fibrin as a Therapy Adjunctive in Patients with Medication-Related Osteonecrosis of the Jaw. J. Clin. Med. 2022, 11, 682. [Google Scholar] [CrossRef]

| Day 1 | Day 3 | Day 5 | |||||||
|---|---|---|---|---|---|---|---|---|---|
| Bonferroni’s Multiple Comparison Test | Mean Diff. | Adjusted p Value | Mean Diff. | Adjusted p Value | Mean Diff. | Adjusted p Value | |||
| BG | |||||||||
| LPRF vs. PLYF | 0.0549 | ns | 0.8859 | 0.07477 | ns | >0.9999 | −0.02683 | ns | >0.9999 |
| LPRF vs. No Exudate | −0.09857 | ns | 0.6808 | −0.0658 | ns | >0.9999 | −0.09123 | ns | 0.5255 |
| PLYF vs. No Exudate | −0.1535 | ns | 0.4051 | −0.1406 | ns | 0.2464 | −0.0644 | ns | 0.9969 |
| CP | |||||||||
| LPRF vs. PLYF | −0.1459 | ns | 0.4402 | −0.0286 | ns | >0.9999 | 0.05997 | ns | >0.9999 |
| LPRF vs. No Exudate | −0.15 | ns | 0.4211 | 0.05177 | ns | >0.9999 | 0.06123 | ns | >0.9999 |
| PLYF vs. No Exudate | −0.0041 | ns | 0.9993 | 0.08033 | ns | 0.9202 | 0.001267 | ns | >0.9999 |
| No Membrane | |||||||||
| LPRF vs. PLYF | 0.009933 | ns | 0.996 | −0.0098 | ns | >0.9999 | −0.03547 | ns | >0.9999 |
| LPRF vs. No Exudate | −0.0844 | ns | 0.753 | −0.0674 | ns | >0.9999 | −0.09417 | ns | 0.4871 |
| PLYF vs. No Exudate | −0.09433 | ns | 0.7026 | −0.0575 | ns | >0.9999 | −0.0587 | ns | >0.9999 |
Disclaimer/Publisher’s Note: The statements, opinions and data contained in all publications are solely those of the individual author(s) and contributor(s) and not of MDPI and/or the editor(s). MDPI and/or the editor(s) disclaim responsibility for any injury to people or property resulting from any ideas, methods, instructions or products referred to in the content. |
© 2025 by the authors. Licensee MDPI, Basel, Switzerland. This article is an open access article distributed under the terms and conditions of the Creative Commons Attribution (CC BY) license (https://creativecommons.org/licenses/by/4.0/).
Share and Cite
Tsang, N.C.W.; Acharya, A.; Pelekos, G. In Vitro Evaluation of the Antibacterial Properties and Cellular Response of Liquid-Leukocyte Platelet-Rich Fibrin Products on Barrier Membranes: A Pilot Study. Dent. J. 2025, 13, 228. https://doi.org/10.3390/dj13060228
Tsang NCW, Acharya A, Pelekos G. In Vitro Evaluation of the Antibacterial Properties and Cellular Response of Liquid-Leukocyte Platelet-Rich Fibrin Products on Barrier Membranes: A Pilot Study. Dentistry Journal. 2025; 13(6):228. https://doi.org/10.3390/dj13060228
Chicago/Turabian StyleTsang, Nichol Chun Wai, Aneesha Acharya, and Georgios Pelekos. 2025. "In Vitro Evaluation of the Antibacterial Properties and Cellular Response of Liquid-Leukocyte Platelet-Rich Fibrin Products on Barrier Membranes: A Pilot Study" Dentistry Journal 13, no. 6: 228. https://doi.org/10.3390/dj13060228
APA StyleTsang, N. C. W., Acharya, A., & Pelekos, G. (2025). In Vitro Evaluation of the Antibacterial Properties and Cellular Response of Liquid-Leukocyte Platelet-Rich Fibrin Products on Barrier Membranes: A Pilot Study. Dentistry Journal, 13(6), 228. https://doi.org/10.3390/dj13060228

